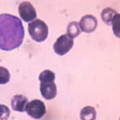

Լրահոս
 Օրվա կադրը՝ սահմանից
Օրվա կադրը՝ սահմանից
 Տեսահոլովակում նկարահանվել են Արցախում զոհված տղաների մայրերը. Սոնա Ռուբենյանը պատմում է «Մայրիկ» երգի մանրամասները
Տեսահոլովակում նկարահանվել են Արցախում զոհված տղաների մայրերը. Սոնա Ռուբենյանը պատմում է «Մայրիկ» երգի մանրամասները
 Տղամարդը կտավներ է ստեղծում գինու կաթիլներով (տեսանյութ)
Տղամարդը կտավներ է ստեղծում գինու կաթիլներով (տեսանյութ)
 Ահա թե ինչպես է հայրը սիրաշահում որդուն (տեսանյութ)
Ահա թե ինչպես է հայրը սիրաշահում որդուն (տեսանյութ)
 Հովհաննես Դավթյանը՝ «Քաղաքում»-ի Մխոն ամուսնալուծվել է (լուսանկար, տեսանյութ)
Հովհաննես Դավթյանը՝ «Քաղաքում»-ի Մխոն ամուսնալուծվել է (լուսանկար, տեսանյութ)
 Ի՞նչպես կարելի է հարստանալ (տեսանյութ)
Ի՞նչպես կարելի է հարստանալ (տեսանյութ)
 Քիմ Քարդաշյանը ցուցադրել է, թե ինչ տեսք կունենա դուստրը, երբ մեծանա
Քիմ Քարդաշյանը ցուցադրել է, թե ինչ տեսք կունենա դուստրը, երբ մեծանա
 Մարգարիտա Բարխոյանը՝ հոր ձերբակալության մասին
Մարգարիտա Բարխոյանը՝ հոր ձերբակալության մասին
 Քարդաշյանի` «WSJ»-ին դատապարտող հոդվածն ու Քլունիի այցը Ծիծեռնակաբերդ` Daily Mail-ում
Քարդաշյանի` «WSJ»-ին դատապարտող հոդվածն ու Քլունիի այցը Ծիծեռնակաբերդ` Daily Mail-ում
 Ինգուշ միլիարդատիրոջ որդու հարսանիքը շարունակվել է Լոնդոնում
Ինգուշ միլիարդատիրոջ որդու հարսանիքը շարունակվել է Լոնդոնում
 «Եվրատեսիլ»-ի մասնակիցը Մարտակերտից ֆրանսերեն տեսանյութով պատմում է ադրբեջանական հրետակոծությունների մասին
«Եվրատեսիլ»-ի մասնակիցը Մարտակերտից ֆրանսերեն տեսանյութով պատմում է ադրբեջանական հրետակոծությունների մասին
 Մարինա Մարտիրոսյան. «Տղայիս էինք համոզում, աղջիկս էր փախչում»
Մարինա Մարտիրոսյան. «Տղայիս էինք համոզում, աղջիկս էր փախչում»
 Գնչու հարսնացուն 63 կիլոգրամանոց հարսանեկան զգեստ է հագել
Գնչու հարսնացուն 63 կիլոգրամանոց հարսանեկան զգեստ է հագել
 «Շատ եմ սիրում նրան և իմ սերը փոխադարձ է». «Քաղաքում»-ի Վարուժի անկեղծ խոստովանությունը սիրելիի մասին
«Շատ եմ սիրում նրան և իմ սերը փոխադարձ է». «Քաղաքում»-ի Վարուժի անկեղծ խոստովանությունը սիրելիի մասին
 Խառնուրդ, որը 5 րոպեում կվերացնի ատամների փառը
Խառնուրդ, որը 5 րոպեում կվերացնի ատամների փառը
 Մեղրը կօգնի փրկել տեսողությունը
Մեղրը կօգնի փրկել տեսողությունը
 Մովսես Երեմյանի եւ Աննայի հարսանեկան լուսանկարները
Մովսես Երեմյանի եւ Աննայի հարսանեկան լուսանկարները
 Facebook-ը շահույթի գրեթե եռակի աճ է արձանագրել
Facebook-ը շահույթի գրեթե եռակի աճ է արձանագրել
 Քիմ Քարդաշյանը ծննդաբերությունից հետո առաջին անգամ հայտնվել է լողազգեստով
Քիմ Քարդաշյանը ծննդաբերությունից հետո առաջին անգամ հայտնվել է լողազգեստով
 Ինչպե՞ս արագ և հեշտ ազատվել մազերի յուղոտվածությունից
Ինչպե՞ս արագ և հեշտ ազատվել մազերի յուղոտվածությունից
 Հոգեբանական թեստ. ընտրեք առավել դուր եկած աթոռն ու բացահայտեք ձեր բնավորության գաղտնի գծերը
Հոգեբանական թեստ. ընտրեք առավել դուր եկած աթոռն ու բացահայտեք ձեր բնավորության գաղտնի գծերը
 Ըմպելիք,որը կօգնի այրել փորի ավելորդ ճարպերը
Ըմպելիք,որը կօգնի այրել փորի ավելորդ ճարպերը
 Ինչու՞ չի կարելի ուտել կարտոֆիլ և սպիտակ հաց
Ինչու՞ չի կարելի ուտել կարտոֆիլ և սպիտակ հաց
 Բուրավետ մոմերը վտանգավոր են առողջության համար. Ո՞ր մոմերն են անվտանգ
Բուրավետ մոմերը վտանգավոր են առողջության համար. Ո՞ր մոմերն են անվտանգ
 Ինչի վրա է փող ծախսում աղջիկների ներկայիս սերունդը
Ինչի վրա է փող ծախսում աղջիկների ներկայիս սերունդը
 Նիհարեք 5 կգ՝ մեկ շաբաթում
Նիհարեք 5 կգ՝ մեկ շաբաթում
 Գիտնականները հայտնել են արյան ագրեսիվ քաղցկեղի դեմ դեղամիջոց ստեղծելու հնարավորության մասին
Գիտնականները հայտնել են արյան ագրեսիվ քաղցկեղի դեմ դեղամիջոց ստեղծելու հնարավորության մասին
 Զարմանալի փաստեր վարունգի մասին
Զարմանալի փաստեր վարունգի մասին
 Ինչու չի կարելի կրծկալ կրել
Ինչու չի կարելի կրծկալ կրել
 Այս թեստը կբացահայտի Ձեր մասին ողջ ճշմարտությունը. Իմացեք, թե ինչ գաղտնիքներ է թաքցնում սեղմած բռունցքը (լուսանկար)
Այս թեստը կբացահայտի Ձեր մասին ողջ ճշմարտությունը. Իմացեք, թե ինչ գաղտնիքներ է թաքցնում սեղմած բռունցքը (լուսանկար)

 Գտնվել է անծանոթի տանը՝ կենդանի. մանրմասներ
Գտնվել է անծանոթի տանը՝ կենդանի. մանրմասներ Գիտությունն այլևս գրավիչ չէ երիտասարդների համար. Ատոմ Մխիթարյան
Գիտությունն այլևս գրավիչ չէ երիտասարդների համար. Ատոմ Մխիթարյան  Համախմբում՝ հանուն երաշխավորված խաղաղության
Համախմբում՝ հանուն երաշխավորված խաղաղության  Որևէ գերտերության աջակցությունը ստանալով՝ նոր ռումբեր ես դնում Հայաստանի տակ, որովհետև աջակցելն անվճար չի լինում․ Նաիրի Սարգսյան
Որևէ գերտերության աջակցությունը ստանալով՝ նոր ռումբեր ես դնում Հայաստանի տակ, որովհետև աջակցելն անվճար չի լինում․ Նաիրի Սարգսյան Ucom-ի գարնանային առաջարկը՝ HONOR X7d 5G սմարթֆոն և արժեքավոր նվերներ
Ucom-ի գարնանային առաջարկը՝ HONOR X7d 5G սմարթֆոն և արժեքավոր նվերներ
 Ինչ արժեն պետությանը հանձնվող շքեղ նվերները
Ինչ արժեն պետությանը հանձնվող շքեղ նվերները Իշխանությունները թոշակների բարձրացումը սարքել են ընտրակաշառք և վարկանիշ բարձրացնելու գործիք. Արմեն Մանվելյան
Իշխանությունները թոշակների բարձրացումը սարքել են ընտրակաշառք և վարկանիշ բարձրացնելու գործիք. Արմեն Մանվելյան  Բարձրագույն դատական խորհրդին կոչ ենք անում հետևողական լինել և հատկապես դատական նիստերին դրսևորել զուսպ ու դատավորներին վայել վարքագիծ
Բարձրագույն դատական խորհրդին կոչ ենք անում հետևողական լինել և հատկապես դատական նիստերին դրսևորել զուսպ ու դատավորներին վայել վարքագիծ Չզարմանաք, որ առաջիկայում Աննային տեսնենք ընդդիմության ցույցեցին. Նաիրա Զոհրաբյան
Չզարմանաք, որ առաջիկայում Աննային տեսնենք ընդդիմության ցույցեցին. Նաիրա Զոհրաբյան Ինչպես են առաջնորդները կառուցում վստահություն. Ակբա բիզնես ակումբ
Ինչպես են առաջնորդները կառուցում վստահություն. Ակբա բիզնես ակումբ Սրճարանում գազի պայթյունի հետևանքով զոհերի թիվը հասել է յոթի
Սրճարանում գազի պայթյունի հետևանքով զոհերի թիվը հասել է յոթի «Ուժեղ Հայաստան» կուսակցության անդամները իրազեկման արշավ են իրականացրել Աբովյան քաղաքում։ Ներկայացրել են Սամվել Կարապետյանի 5 տնտեսական քայլերը
«Ուժեղ Հայաստան» կուսակցության անդամները իրազեկման արշավ են իրականացրել Աբովյան քաղաքում։ Ներկայացրել են Սամվել Կարապետյանի 5 տնտեսական քայլերը
 Գիտելիքով հարուստ` ստեղծագործող մտքին է միայն հատուկ փոփոխություններ բերել և ավելի լավ ապագա կառուցել. կառուցել Ուժեղ Հայաստան. Տաթևիկ Կարապետյան
Գիտելիքով հարուստ` ստեղծագործող մտքին է միայն հատուկ փոփոխություններ բերել և ավելի լավ ապագա կառուցել. կառուցել Ուժեղ Հայաստան. Տաթևիկ Կարապետյան Եթե կա պատրանք, թե Հայաստանում մոլդովական սցենարի դեպքում Մոսկվայից կլինի ինչ-որ աջակցություն կամ ռեակցիա, ապա արժի հիշել նույն Մոլդովայի օրինակը․ Հովհաննիսյան
Եթե կա պատրանք, թե Հայաստանում մոլդովական սցենարի դեպքում Մոսկվայից կլինի ինչ-որ աջակցություն կամ ռեակցիա, ապա արժի հիշել նույն Մոլդովայի օրինակը․ Հովհաննիսյան
 Երկու առևտրական ձերբակալվել են միրգը վաճառելուց առաջ թունավորելու համար. Զգուշացում
Երկու առևտրական ձերբակալվել են միրգը վաճառելուց առաջ թունավորելու համար. Զգուշացում ԶՊՄԿ-Կառավարություն-Համայնք համատեղ աշխատանքի արդյունքում Քաջարանը դարձել է ամենաբարեկեցիկ և ամենացածր գործազրկություն ունեցող համայնքներից մեկը
ԶՊՄԿ-Կառավարություն-Համայնք համատեղ աշխատանքի արդյունքում Քաջարանը դարձել է ամենաբարեկեցիկ և ամենացածր գործազրկություն ունեցող համայնքներից մեկը Աննայի որոշմանը վերաբերվում եմ հարգանքով․ Փաշինյան
Աննայի որոշմանը վերաբերվում եմ հարգանքով․ Փաշինյան
 «ՀայաՔվեն» բարձրացնելու է միջին կենսաթոշակը 50%֊ով. Մենուա Սողոմոնյան
«ՀայաՔվեն» բարձրացնելու է միջին կենսաթոշակը 50%֊ով. Մենուա Սողոմոնյան  Մենք ոգեկոչում ենք սումգայիթյան ջարդերի զոհերի հիշատակը՝ հայ ժողովրդի հանդեպ նման ոճրագործությունները կանխելու հանձնառությամբ. Արշակ Կարապետյան
Մենք ոգեկոչում ենք սումգայիթյան ջարդերի զոհերի հիշատակը՝ հայ ժողովրդի հանդեպ նման ոճրագործությունները կանխելու հանձնառությամբ. Արշակ Կարապետյան Ադրբեջանն իր ողջ ռեսուրսը մեծացնում և ընդլայնում է՝ հայ ժողովրդին իր բնօրրանից քշելու և ագրեuիան ամբողջացնելու համար․ Տիգրան Աբրահամյան
Ադրբեջանն իր ողջ ռեսուրսը մեծացնում և ընդլայնում է՝ հայ ժողովրդին իր բնօրրանից քշելու և ագրեuիան ամբողջացնելու համար․ Տիգրան Աբրահամյան
 Իսկ հայերը կարող են Ստեփանակերտ, Շուշի այցելել. Էդմոն Մարուքյան
Իսկ հայերը կարող են Ստեփանակերտ, Շուշի այցելել. Էդմոն Մարուքյան  Այն մասին, թե ինչպես մենք պետք է իրական և հարատև խաղաղություն ապահովենք. Ավետիք Չալաբյան
Այն մասին, թե ինչպես մենք պետք է իրական և հարատև խաղաղություն ապահովենք. Ավետիք Չալաբյան Արժեհամակարգի ճգնաժամ և իշխանության պատասխանատվությունը
Արժեհամակարգի ճգնաժամ և իշխանության պատասխանատվությունը Տասը հազար դրամի խոստումը և արժանապատիվ կյանքի հարցը
Տասը հազար դրամի խոստումը և արժանապատիվ կյանքի հարցը Ռուբլին էժանացել է․ փոխարժեքն՝ այսօր
Ռուբլին էժանացել է․ փոխարժեքն՝ այսօր
 Աղոթք ճանապարհ գնալուց առաջ
Աղոթք ճանապարհ գնալուց առաջ
 Կյանքից հեռացել է «Բանակում» սերիալից հայտնի Գոռ Հարությունյանի եղբայրը
Կյանքից հեռացել է «Բանակում» սերիալից հայտնի Գոռ Հարությունյանի եղբայրը Վիճաբանել ու հայհոյել են․ նոր մանրամասներ՝ զինծառայողի սպանության դեպքից
Վիճաբանել ու հայհոյել են․ նոր մանրամասներ՝ զինծառայողի սպանության դեպքից Թուրք և ռուս պաշտոնյանները քննարկել են հայ-ադրբեջանական կարգավորման գործընթացը
Թուրք և ռուս պաշտոնյանները քննարկել են հայ-ադրբեջանական կարգավորման գործընթացը Հայտնաբերվել է մեծ քանակի զենք-զինամթերք
Հայտնաբերվել է մեծ քանակի զենք-զինամթերք Պետական անտարբերություն՝ առաջին խմբի հաշմանդամություն ունեցող ծնողին զրկել են կենսաթոշակից . Տեսանյութ
Պետական անտարբերություն՝ առաջին խմբի հաշմանդամություն ունեցող ծնողին զրկել են կենսաթոշակից . Տեսանյութ ՊՆ-ն հաստատեց․ հայտնաբերվել է զինծառայողի մարմին
ՊՆ-ն հաստատեց․ հայտնաբերվել է զինծառայողի մարմին Նիկոլ Փաշինյանը հանդիպում է ունեցել Լեհաստանի նախագահի հետ
Նիկոլ Փաշինյանը հանդիպում է ունեցել Լեհաստանի նախագահի հետ Գեղարքունիքի մարզում հայտնաբերվել է 19-ամյա զինվորի մարմինը մարտական դիրքում․ կասկածյալը հայտնաբերվել է.
Գեղարքունիքի մարզում հայտնաբերվել է 19-ամյա զինվորի մարմինը մարտական դիրքում․ կասկածյալը հայտնաբերվել է.  Ո՞վ ասաց, որ իրենք մնան, պատերազմ չի լինելու. քաղաքացիները՝ Երաշխավորված խաղաղություն կոնցեպտի մասին
Ո՞վ ասաց, որ իրենք մնան, պատերազմ չի լինելու. քաղաքացիները՝ Երաշխավորված խաղաղություն կոնցեպտի մասին 110 միլիոն՝ իշխանությանը, 10 000 դրամ՝ թոշակառուներին. ո՞ւր է գնում պետբյուջեն. Էդմոն Մարուքյան
110 միլիոն՝ իշխանությանը, 10 000 դրամ՝ թոշակառուներին. ո՞ւր է գնում պետբյուջեն. Էդմոն Մարուքյան Փոքրիկ խմբակի ստերը․ Դավիթ Ղազինյան
Փոքրիկ խմբակի ստերը․ Դավիթ Ղազինյան Նարեկ Կարապետյանի հանդիպումը երիտասարդների հետ․ ներկայացվել է նաև քաղաքական IA բոտը
Նարեկ Կարապետյանի հանդիպումը երիտասարդների հետ․ ներկայացվել է նաև քաղաքական IA բոտը Մեր ծրագրում եղել և շարունակում է մնալ ներառված․ «Նվազագույն կենսաթոշակը դառնալու է 100000 դրամ, իսկ թե ինչպես, կիմանաք, երբ ներկայացնենք մեր ծրագիրը». Նաիրի Սարգսյան
Մեր ծրագրում եղել և շարունակում է մնալ ներառված․ «Նվազագույն կենսաթոշակը դառնալու է 100000 դրամ, իսկ թե ինչպես, կիմանաք, երբ ներկայացնենք մեր ծրագիրը». Նաիրի Սարգսյան Բռնցքամարտիկ Անուշ Գրիգորյանը առաջին մեդալը ապահովեց Ստրանջայի մրցաշարում
Բռնցքամարտիկ Անուշ Գրիգորյանը առաջին մեդալը ապահովեց Ստրանջայի մրցաշարում Ինչպիսին է ավտոճանապարհների վիճակն այս պահի դրությամբ․ տեղ-տեղ առկա է մերկասառույց
Ինչպիսին է ավտոճանապարհների վիճակն այս պահի դրությամբ․ տեղ-տեղ առկա է մերկասառույց Су-30 СМ կործանիչ ինքնաթիռ է կործանվել
Су-30 СМ կործանիչ ինքնաթիռ է կործանվել Կրոնական ազատությունը վտանգի տակ․ Հայաստան, Արցախ և միջազգային պատասխանատվություն․ Սամվել Կարապետյան
Կրոնական ազատությունը վտանգի տակ․ Հայաստան, Արցախ և միջազգային պատասխանատվություն․ Սամվել Կարապետյան Գեղարքունիքի մարզի զորամասերից մեկում զինվոր է մահացել. նախնական վարկածով սպանել են
Գեղարքունիքի մարզի զորամասերից մեկում զինվոր է մահացել. նախնական վարկածով սպանել են Իրան-ԱՄՆ բանակցությունները ընդմիջվել են
Իրան-ԱՄՆ բանակցությունները ընդմիջվել են
 Սուրեն Պապիկյանի գյուղում բարեգործության անվան տակ ընտրակաշա՞ռք են բաժանում, «Փաստինֆո»-ի հարցադրումից հետո ֆեյսբուքյան էջից հայտարարությունը հեռացվել է
Սուրեն Պապիկյանի գյուղում բարեգործության անվան տակ ընտրակաշա՞ռք են բաժանում, «Փաստինֆո»-ի հարցադրումից հետո ֆեյսբուքյան էջից հայտարարությունը հեռացվել է Վեգա ընկերության և «Մերիդիան» էքսպո կենտրոնի միջև ստորագրվեց փոխըմբռնման հուշագիր
Վեգա ընկերության և «Մերիդիան» էքսպո կենտրոնի միջև ստորագրվեց փոխըմբռնման հուշագիր
 Թույլերին խաղաղություն չեն տալիս․ Ավետիք Չալաբյան
Թույլերին խաղաղություն չեն տալիս․ Ավետիք Չալաբյան Գեղարքունիքի մարզի N զորամասում զինվոր է մահացել
Գեղարքունիքի մարզի N զորամասում զինվոր է մահացել
Նոր խստացում վարորդների համար
Նոր խստացում վարորդների համար 





